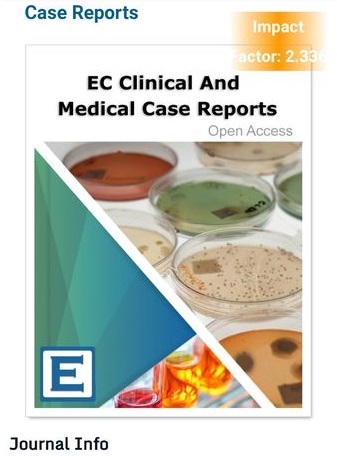
Case_report_10.22

Лікар ПСИХОТЕРАПЕВТ
вчений, автор методу REAVISIA - ревізія та активація життя
член Всесвітньої асоціації Позитивної та Транскультуральної Психотерапії
та Європейської асоціації Клінічної Психології та Психотерапії
Вперше
метод REAVISIA = ефективна робота із ПРИЧИНАМИ проблем у житті та психічному стані
Панічні атаки, тривожність нав'язливі думки, страхи
тепер можна подолати за 1-2 тижні
Апатія Депресія Вигоряння
прокрастинація, втрата сенсів
Невдачі у відносинах
повторювані події, самотність, аб'юз, чергові "граблі" особистого життя
Блоки у грошах
прокрастинація, фінансова стеля, борги, демотивація, втрати грошей
Фігура Булімія РХП
анорексія, заїдання, неконтролюєма повнота
Залежності та ОКР
химічні, поведінкові, особисті
"Сьогодні звернулася за допомогою до вас уже з третім своїм запитом. І знову я в захваті і сповнена подяки. Але при цьому ще у величезному подиві від отриманого результату! Ваш метод справді чарівний" Інна
Складні та незрозумілі хвороби
психосоматичні причини нездоров'я
"Я дуже рада, що випадково знайшла вас на просторах інтернету. Але думаю це не була випадковість. Дякую)" Інна
Події, що повторюються
"спадкова" схильність до хвороб; невдачі в грошах та відносинах, які повторюються
" У мене справи набагато кращі. На події в житті стала реагувати спокійніше і не "вмирати" місяцями, а за лічені хвилини приводити себе в себе. Син навіть родичам почав говорити, що мама стала спокійнішою і адекватнішою". Олена
Проблеми у ДІТЕЙ
психологічні, РХП, залежності, здоров'я
До мене звертаються
Найскладніші та заплутані випадки
навіть після багаторічних спроб знайти допомогу у психології, психіатрії, езотериці, релігії
Чому саме REAVISIA
Вперше ми можемо знайти ПРИЧИНИ ваших психологічних та життєвих проблем
Вперше за 1 сеанс знаходиться і нейтралізується цілий ланцюг психотравм, сімейних сценаріїв та психо-емоційних вкидів, які створили вашу проблему.
Тому принцип методу - не "година роботи" із проявами-симптомами - так місяцями і роками,
а СЕАНС "від і до"...якій триває 1,5-2 години
Тепер 80% проблем можна вирішити за 1-2 сеанси, прибравши ПРИЧИНИ
Авторські психологичні тести
Доказова психотерапія
метод REAVISIA
"Хочу подякувати своєму тепер докторові, який допоміг мені вийти з стану такого ,що словами не передати і за один сеанс, без таблеток яких я боюся. Допоміг пережити втрату мами яка мучила мене 6 років...Дуже Вам Велике Дякую
Ви вернули мене до життя." Анна
Про метод
Метод REAVISIA - можливисть знайти справжні ПРИЧИНИ ваших проблем.
Зазвичай, це на 70-80% сімейні сценарії - комплекс упереджень, заборон, установок, обмежень, справжніх "вірусів" підсвідомості - наслідків подій в житті ваших рідних - ті, що передані вам у дитинстві
+ 10-20% - це психо-емоційний вплив інших людей насамперед із мотивів ЗАЗДРОСТІ та ПОМСТИ
+ лише 10-20% - наслідки самие психотравм, помилок, невдач вашого життя
"Після кожної сесії з мене як бетонну плиту знімають, така легкість настає і багато, багато сил йти вперед.
Я всім рекомендую вас як фахівця, який дійсно допомагає! Ще раз Дякую!)" Світлана
Що таке СЦЕНАРІЇ ?
Як виправити ваше життя?
розберемося у вашій проблемі та плані її вирішення

Багато корисного